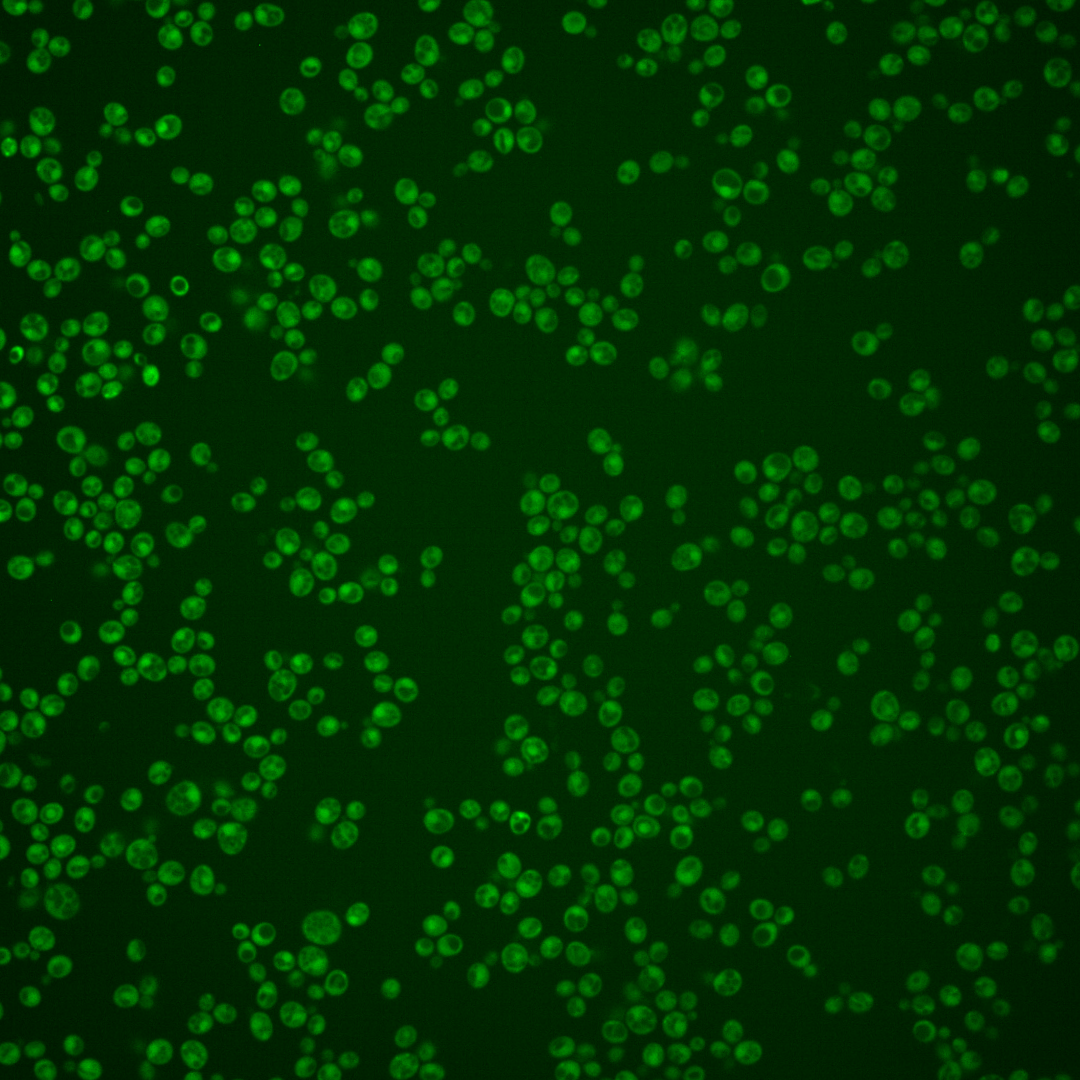
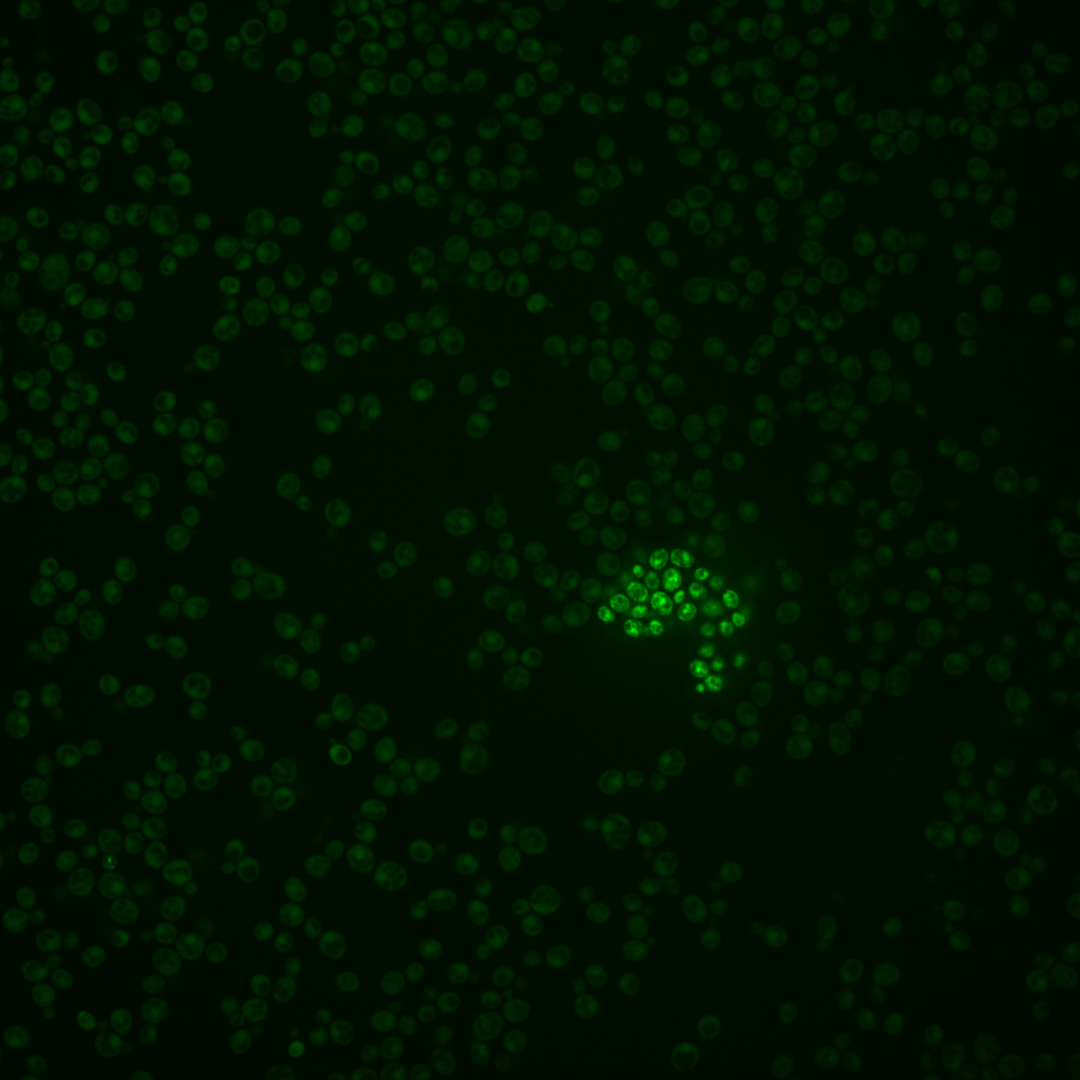
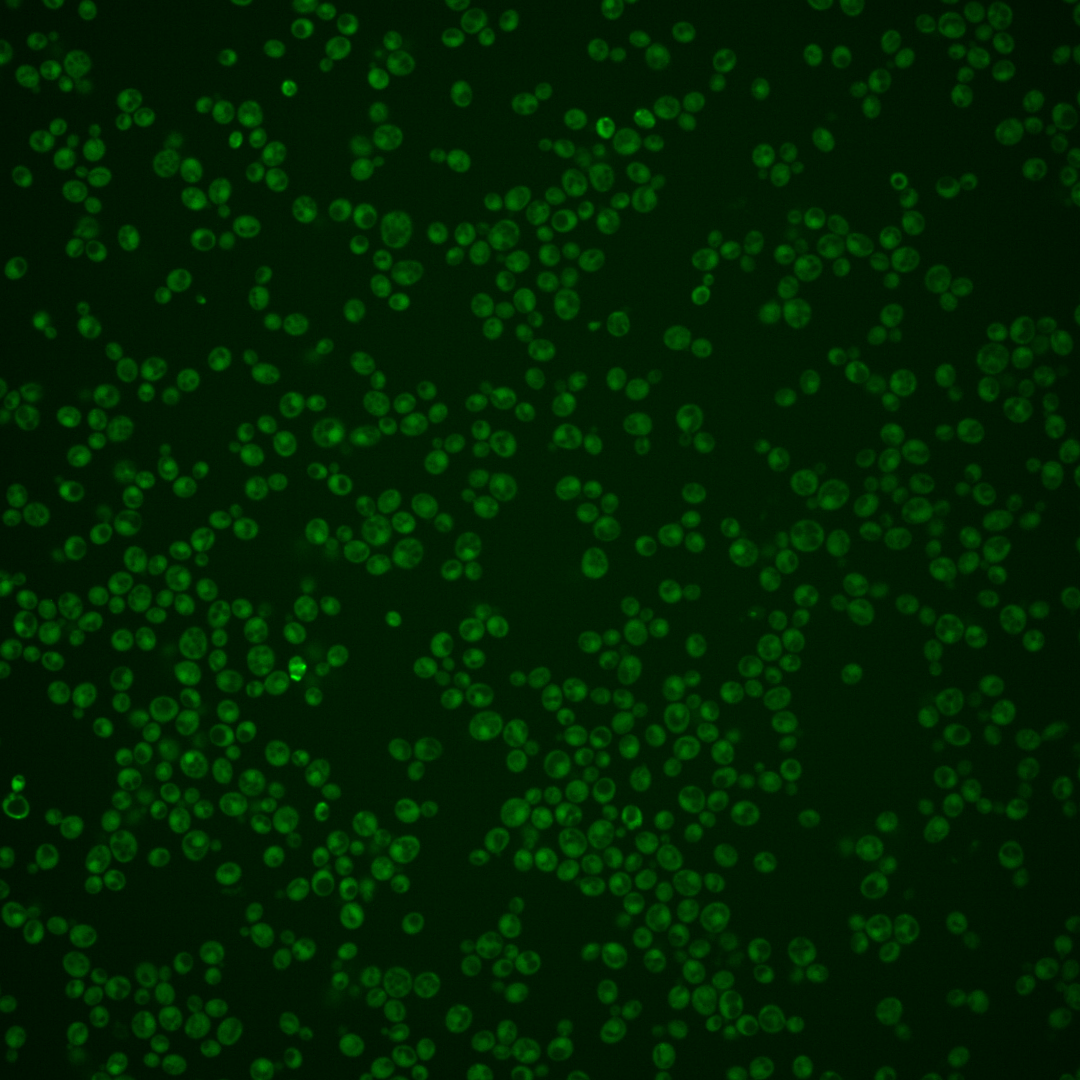
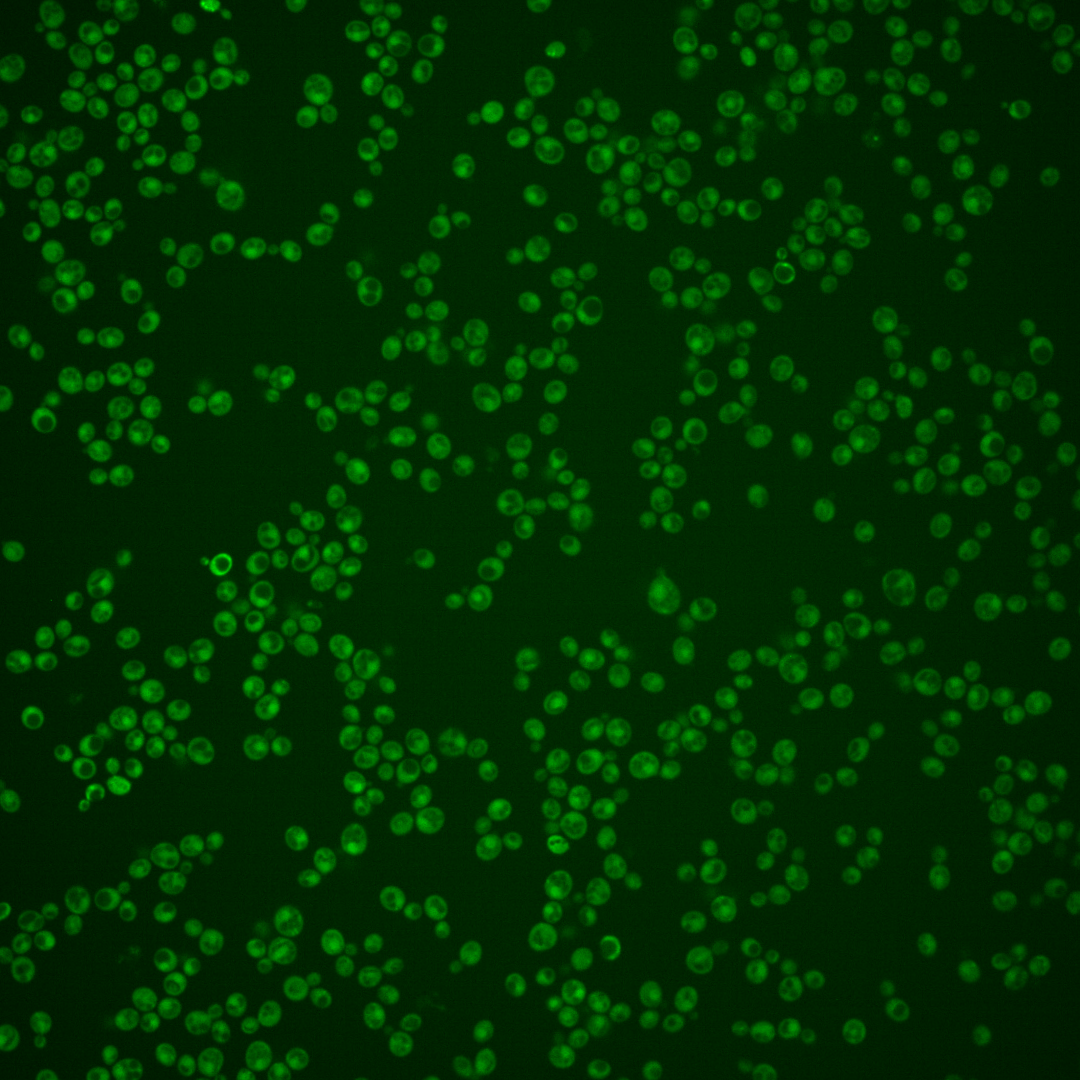

| Standard name | |
|---|---|
| Human Ortholog | |
| Description | Possible shared subunit of Cop9 signalosome (CSN) and eIF3; binds eIF3b subunit Prt1p, has possible dual functions in transcriptional and translational control, contains a PCI (Proteasome-COP9 signalosome (CSN)-eIF3) domain |
Micrographs




















































































Sub-cellular Localization
Yeast GFP Assignment
Protein Abundance
Localization Change
External localization resources
| ensLOC | DeepLoc | |||||||||||||||||||||||
|---|---|---|---|---|---|---|---|---|---|---|---|---|---|---|---|---|---|---|---|---|---|---|---|---|
| Localization | WT1 | WT2 | WT3 | RAP60 | RAP140 | RAP220 | RAP300 | RAP380 | RAP460 | RAP540 | RAP620 | RAP700 | HU80 | HU120 | HU160 | rpd3Δ_1 | rpd3Δ_2 | rpd3Δ_3 | WT1 | WT2 | WT3 | AF100 | AF140 | AF180 |
| Cortical Patches | 0 | 0 | 0 | 0 | 0 | 0 | 0 | 0 | 0 | 0 | 0 | 0 | 0 | 0 | 0 | 0 | 0 | 0 | 1 | 1 | 5 | 0 | 3 | 5 |
| Bud | 0 | 1 | 1 | 2 | 5 | 3 | 26 | 16 | 18 | 22 | 17 | 25 | 0 | 0 | 0 | 0 | 0 | 1 | 0 | 0 | 1 | 0 | 8 | 13 |
| Bud Neck | 0 | 1 | 1 | 1 | 0 | 3 | 1 | 2 | 0 | 0 | 0 | 1 | 1 | 1 | 0 | 0 | 0 | 1 | 1 | 0 | 1 | 0 | 2 | 2 |
| Bud Site | 0 | 0 | 1 | 1 | 0 | 1 | 1 | 0 | 2 | 7 | 3 | 3 | 0 | 0 | 0 | 0 | 0 | 0 | – | – | – | – | – | – |
| Cell Periphery | 0 | 0 | 3 | 4 | 2 | 1 | 3 | 1 | 1 | 4 | 5 | 4 | 1 | 0 | 0 | 0 | 0 | 3 | 0 | 0 | 4 | 0 | 0 | 0 |
| Cytoplasm | 200 | 226 | 575 | 537 | 614 | 611 | 768 | 834 | 537 | 687 | 523 | 615 | 287 | 409 | 467 | 242 | 357 | 237 | 188 | 212 | 486 | 235 | 436 | 429 |
| Endoplasmic Reticulum | 1 | 0 | 2 | 0 | 0 | 1 | 2 | 1 | 1 | 1 | 3 | 1 | 0 | 1 | 0 | 5 | 28 | 10 | 0 | 0 | 2 | 1 | 2 | 1 |
| Endosome | 0 | 0 | 1 | 0 | 5 | 0 | 3 | 8 | 1 | 3 | 1 | 4 | 0 | 0 | 3 | 5 | 5 | 1 | 2 | 1 | 6 | 1 | 2 | 5 |
| Golgi | 0 | 0 | 1 | 0 | 0 | 0 | 1 | 0 | 0 | 0 | 0 | 0 | 1 | 0 | 0 | 2 | 1 | 0 | 0 | 0 | 5 | 0 | 2 | 4 |
| Mitochondria | 22 | 9 | 17 | 77 | 101 | 286 | 589 | 272 | 413 | 562 | 558 | 578 | 0 | 0 | 1 | 6 | 7 | 5 | 13 | 3 | 61 | 2 | 11 | 12 |
| Nucleus | 0 | 2 | 0 | 1 | 1 | 5 | 14 | 4 | 11 | 14 | 5 | 8 | 0 | 0 | 0 | 1 | 3 | 5 | 0 | 1 | 0 | 0 | 3 | 2 |
| Nuclear Periphery | 1 | 0 | 1 | 0 | 0 | 0 | 6 | 1 | 3 | 0 | 2 | 5 | 0 | 0 | 0 | 0 | 0 | 0 | 0 | 0 | 1 | 0 | 0 | 1 |
| Nucleolus | 0 | 0 | 0 | 0 | 2 | 0 | 1 | 4 | 2 | 1 | 0 | 5 | 0 | 0 | 0 | 0 | 1 | 0 | 0 | 0 | 0 | 0 | 0 | 0 |
| Peroxisomes | 0 | 0 | 1 | 0 | 0 | 1 | 0 | 0 | 0 | 0 | 0 | 0 | 0 | 0 | 0 | 0 | 0 | 0 | 0 | 0 | 1 | 0 | 0 | 0 |
| SpindlePole | 0 | 0 | 3 | 0 | 2 | 1 | 1 | 11 | 1 | 2 | 3 | 2 | 0 | 1 | 1 | 0 | 0 | 0 | 2 | 0 | 4 | 0 | 6 | 12 |
| Vac/Vac Membrane | 1 | 2 | 3 | 6 | 16 | 32 | 43 | 34 | 64 | 63 | 60 | 79 | 1 | 3 | 7 | 48 | 79 | 41 | 2 | 2 | 3 | 2 | 9 | 7 |
| Unique Cell Count | 213 | 231 | 593 | 561 | 651 | 779 | 1123 | 1044 | 798 | 1048 | 903 | 993 | 289 | 412 | 474 | 284 | 404 | 274 | 220 | 229 | 595 | 251 | 499 | 507 |
| Labelled Cell Count | 225 | 241 | 610 | 629 | 748 | 945 | 1459 | 1188 | 1054 | 1366 | 1180 | 1330 | 291 | 415 | 479 | 309 | 481 | 304 | 220 | 229 | 595 | 251 | 499 | 507 |
Yeast GFP Assignment
Protein Abundance
| Screen | WT1 | WT2 | WT3 | RAP60 | RAP140 | RAP220 | RAP300 | RAP380 | RAP460 | RAP540 | RAP620 | RAP700 | HU80 | HU120 | HU160 | rpd3Δ_1 | rpd3Δ_2 | rpd3Δ_3 | AF100 | AF140 | AF180 |
|---|---|---|---|---|---|---|---|---|---|---|---|---|---|---|---|---|---|---|---|---|---|
| Mean Cell GFP Intensity (1e-4) | 3.3 | 4.0 | 3.8 | 3.5 | 4.0 | 3.3 | 3.3 | 3.7 | 3.3 | 3.2 | 3.0 | 3.0 | 5.3 | 5.4 | 5.6 | 6.0 | 6.1 | 5.3 | 5.4 | 5.6 | 5.7 |
| Std Deviation (1e-4) | 0.6 | 0.8 | 0.8 | 1.2 | 1.6 | 1.4 | 1.1 | 1.4 | 1.3 | 0.8 | 0.9 | 0.7 | 0.9 | 1.3 | 8.0 | 1.3 | 1.7 | 1.1 | 1.5 | 1.3 | 1.3 |
| Intensity Change (Log2) | – | – | – | -0.11 | 0.05 | -0.21 | -0.2 | -0.07 | -0.21 | -0.26 | -0.37 | -0.33 | 0.46 | 0.48 | 0.54 | 0.63 | 0.66 | 0.47 | 0.5 | 0.56 | 0.57 |
Localization Change
| Localization | RAP60 | RAP140 | RAP220 | RAP300 | RAP380 | RAP460 | RAP540 | RAP620 | RAP700 | HU80 | HU120 | HU160 | rpd3Δ_1 | rpd3Δ_2 | rpd3Δ_3 |
|---|---|---|---|---|---|---|---|---|---|---|---|---|---|---|---|
| Actin | – | – | – | – | – | – | – | – | – | – | – | – | – | – | – |
| Bud | – | – | – | – | – | – | – | – | – | – | – | – | 0 | 0 | 0 |
| Bud Neck | – | – | – | – | – | – | – | – | – | – | – | – | 0 | 0 | 0 |
| Bud Site | – | – | – | – | – | – | – | – | – | – | – | – | 0 | 0 | 0 |
| Cell Periphery | – | – | – | – | – | – | – | – | – | – | – | – | 0 | 0 | 0 |
| Cyto | – | – | – | – | – | – | – | – | – | – | – | – | – | – | – |
| Endoplasmic Reticulum | – | – | – | – | – | – | – | – | – | – | – | – | 0 | 0 | 0 |
| Endosome | – | – | – | – | – | – | – | – | – | – | – | – | 0 | 0 | 0 |
| Golgi | – | – | – | – | – | – | – | – | – | – | – | – | 0 | 0 | 0 |
| Mitochondria | – | – | – | – | – | – | – | – | – | – | – | – | 0 | 0 | 0 |
| Nuclear Periphery | – | – | – | – | – | – | – | – | – | – | – | – | 0 | 0 | 0 |
| Nuc | – | – | – | – | – | – | – | – | – | – | – | – | – | – | – |
| Nucleolus | – | – | – | – | – | – | – | – | – | – | – | – | 0 | 0 | 0 |
| Peroxisomes | – | – | – | – | – | – | – | – | – | – | – | – | 0 | 0 | 0 |
| SpindlePole | – | – | – | – | – | – | – | – | – | – | – | – | 0 | 0 | 0 |
| Vac | – | – | – | – | – | – | – | – | – | – | – | – | – | – | – |
| Cortical Patches | – | – | – | – | – | – | – | – | – | – | – | – | 0 | 0 | 0 |
| Cytoplasm | – | – | – | – | – | – | – | – | – | – | – | – | 0 | 0 | 0 |
| Nucleus | – | – | – | – | – | – | – | – | – | – | – | – | 0 | 0 | 0 |
| Vacuole | – | – | – | – | – | – | – | – | – | – | – | – | 9.7 | 10.7 | 9.0 |
External localization resources
Images






























Protein Concentration and Protein Localization Data
| R1 | R2 | R3 | ||||||||||||||||
|---|---|---|---|---|---|---|---|---|---|---|---|---|---|---|---|---|---|---|
| G1 Pre-START | G1 Post-START | S/G2 | Metaphase | Anaphase | Telophase | G1 Pre-START | G1 Post-START | S/G2 | Metaphase | Anaphase | Telophase | G1 Pre-START | G1 Post-START | S/G2 | Metaphase | Anaphase | Telophase | |
| Concentration | 3.6831 | 4.0247 | 3.9512 | 3.4698 | 3.7136 | 3.9429 | -0.7607 | -0.0194 | -0.3701 | -0.3777 | -0.6409 | -0.3444 | -1.5279 | -0.4159 | -0.852 | -0.5044 | -1.0629 | -1.102 |
| Actin | 0.0056 | 0.0007 | 0.0034 | 0.0007 | 0.0026 | 0.0016 | 0.0269 | 0.0002 | 0.0122 | 0.0001 | 0.0008 | 0.002 | 0.0029 | 0.0003 | 0.0002 | 0.0001 | 0.0006 | 0.0004 |
| Bud | 0.002 | 0.0009 | 0.0076 | 0.0031 | 0.0034 | 0.0043 | 0.0003 | 0.0037 | 0.0005 | 0 | 0.0004 | 0.0011 | 0 | 0.0002 | 0.0006 | 0.0001 | 0.0003 | 0.0002 |
| Bud Neck | 0.0003 | 0.0004 | 0.0023 | 0.0003 | 0.001 | 0.003 | 0.0035 | 0.0001 | 0.0022 | 0.0001 | 0.0202 | 0.0023 | 0.0001 | 0.0001 | 0.0017 | 0.0002 | 0.0001 | 0.0011 |
| Bud Periphery | 0.0035 | 0.001 | 0.0027 | 0.0064 | 0.0088 | 0.0059 | 0.0005 | 0.0008 | 0.0006 | 0 | 0.0004 | 0.0015 | 0 | 0.0001 | 0.0003 | 0 | 0.0005 | 0.0001 |
| Bud Site | 0.0022 | 0.0311 | 0.0097 | 0.0018 | 0.0007 | 0.0023 | 0.0021 | 0.0013 | 0.0022 | 0 | 0.0016 | 0.0003 | 0.0002 | 0.0026 | 0.009 | 0.0002 | 0.0001 | 0.0004 |
| Cell Periphery | 0.0004 | 0.0002 | 0.0002 | 0.0002 | 0.0004 | 0.0007 | 0.0001 | 0.0001 | 0.0001 | 0 | 0.0001 | 0.0001 | 0 | 0.0001 | 0.0001 | 0 | 0 | 0 |
| Cytoplasm | 0.065 | 0.0702 | 0.0774 | 0.054 | 0.1115 | 0.1143 | 0.2334 | 0.4212 | 0.3348 | 0.3261 | 0.2358 | 0.4152 | 0.225 | 0.3483 | 0.3404 | 0.462 | 0.4255 | 0.3876 |
| Cytoplasmic Foci | 0.0134 | 0.0152 | 0.008 | 0.0228 | 0.0137 | 0.0069 | 0.0184 | 0.0083 | 0.01 | 0.0065 | 0.0235 | 0.0161 | 0.0033 | 0.0032 | 0.0144 | 0.0084 | 0.01 | 0.012 |
| Eisosomes | 0.0003 | 0.0005 | 0.0002 | 0.0001 | 0.0003 | 0.0002 | 0.0002 | 0.0001 | 0.0002 | 0 | 0.0001 | 0 | 0.0001 | 0.0002 | 0.0001 | 0 | 0 | 0 |
| Endoplasmic Reticulum | 0.002 | 0.0007 | 0.002 | 0.0011 | 0.0017 | 0.0017 | 0.0031 | 0.0022 | 0.0017 | 0.0015 | 0.0014 | 0.0014 | 0.0015 | 0.0015 | 0.0017 | 0.0025 | 0.0037 | 0.0017 |
| Endosome | 0.0016 | 0.0003 | 0.0028 | 0.0007 | 0.001 | 0.0016 | 0.014 | 0.0015 | 0.0031 | 0.0028 | 0.0094 | 0.0049 | 0.0019 | 0.0008 | 0.0126 | 0.0084 | 0.0104 | 0.0032 |
| Golgi | 0.0004 | 0.0001 | 0.0007 | 0.0001 | 0.0002 | 0.0002 | 0.0044 | 0.0002 | 0.001 | 0.0001 | 0.0023 | 0.0004 | 0.0004 | 0.0001 | 0.0008 | 0.0001 | 0.0003 | 0.0002 |
| Lipid Particles | 0.0007 | 0.0003 | 0.0007 | 0.0011 | 0.0004 | 0.0005 | 0.0041 | 0.0004 | 0.0006 | 0.0001 | 0.0015 | 0.0003 | 0.0009 | 0.0001 | 0.0006 | 0.0001 | 0.0002 | 0.0003 |
| Mitochondria | 0.0008 | 0.0006 | 0.0011 | 0.001 | 0.0007 | 0.0007 | 0.0016 | 0.001 | 0.0068 | 0.0002 | 0.0006 | 0.0004 | 0.0003 | 0.0001 | 0.0004 | 0.0003 | 0.0003 | 0.0002 |
| None | 0.8732 | 0.8694 | 0.8579 | 0.8717 | 0.8368 | 0.8419 | 0.6591 | 0.5534 | 0.6143 | 0.6559 | 0.689 | 0.5383 | 0.7581 | 0.6386 | 0.6044 | 0.504 | 0.5383 | 0.5831 |
| Nuclear Periphery | 0.0041 | 0.0005 | 0.0047 | 0.0013 | 0.0009 | 0.002 | 0.0067 | 0.0006 | 0.001 | 0.0011 | 0.002 | 0.0016 | 0.0009 | 0.0006 | 0.0009 | 0.0025 | 0.0025 | 0.0008 |
| Nucleolus | 0.0012 | 0.0011 | 0.0018 | 0.0032 | 0.0008 | 0.0006 | 0.001 | 0.0003 | 0.0002 | 0.0001 | 0.0006 | 0.0003 | 0.0002 | 0.0001 | 0.0004 | 0.0002 | 0.0001 | 0.0004 |
| Nucleus | 0.0131 | 0.0018 | 0.0051 | 0.0046 | 0.0023 | 0.003 | 0.0031 | 0.002 | 0.0028 | 0.0026 | 0.0032 | 0.0072 | 0.0013 | 0.0019 | 0.0069 | 0.0062 | 0.0026 | 0.0032 |
| Peroxisomes | 0.0006 | 0.0002 | 0.0004 | 0.0004 | 0.0004 | 0.0002 | 0.0062 | 0.0003 | 0.0024 | 0.0001 | 0.0016 | 0.0006 | 0.0008 | 0.0001 | 0.0004 | 0.0001 | 0.0001 | 0.0002 |
| Punctate Nuclear | 0.0085 | 0.0046 | 0.0102 | 0.0238 | 0.011 | 0.0072 | 0.0099 | 0.0015 | 0.0026 | 0.0014 | 0.0032 | 0.0047 | 0.0018 | 0.0007 | 0.0009 | 0.0022 | 0.0011 | 0.0042 |
| Vacuole | 0.001 | 0.0003 | 0.0009 | 0.0012 | 0.001 | 0.0008 | 0.0009 | 0.0007 | 0.0007 | 0.0011 | 0.0019 | 0.0009 | 0.0002 | 0.0004 | 0.0031 | 0.002 | 0.0027 | 0.0005 |
| Vacuole Periphery | 0.0003 | 0 | 0.0003 | 0.0004 | 0.0002 | 0.0003 | 0.0006 | 0.0001 | 0.0002 | 0.0002 | 0.0003 | 0.0002 | 0.0001 | 0 | 0.0002 | 0.0004 | 0.0006 | 0.0001 |
Sequencing Data
| R1 | R2 | |||||||||
|---|---|---|---|---|---|---|---|---|---|---|
| G1 Post-START | S/G2 | Metaphase | Anaphase | Telophase | G1 Post-START | S/G2 | Metaphase | Anaphase | Telophase | |
| Gene Expression | 1.2398 | 3.6943 | 3.8379 | 6.2375 | 6.4297 | 4.1303 | 7.4706 | 6.0506 | 5.5271 | 8.0853 |
| Translational Efficiency | – | – | – | – | – | – | – | – | – | – |
Hit Data
| Dataset | Hit |
|---|---|
| Protein Concentration | ✘ |
| Protein Localization | ✘ |
| Gene Expression | ✘ |
| Translational Efficiency | – |
Endocytosis
| Temp | Actin Patch (Sac6-tdTomato) | Cortical Patch (Sla1-GFP) | Late Endosome (Snf7-GFP) | Vacuole (Vph1-GFP) |
|---|---|---|---|---|
| 37℃ | ||||
| RT |
Cell Cycle Omics
CYCLoPs (Pci8-GFP)
| Gene / Allele | Actin Patch (Sac6-tdTomato) | Cortical Patch (Sla1-GFP) | Late Endosome (Snf7-GFP) | Vacuole (Sac6-tdTomato) |
|---|
| Gene | Images |
|---|
| Gene | Images |
|---|
Images are not yet available
Images are not yet available